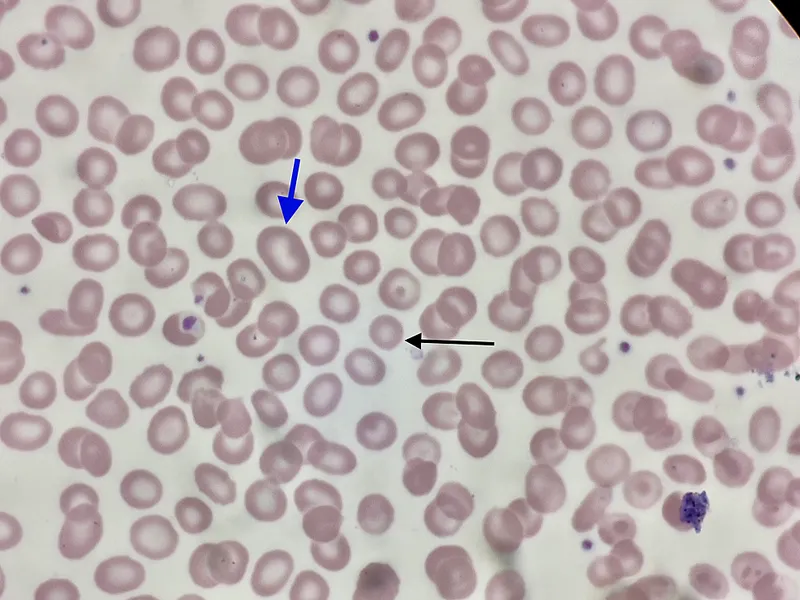
Peripheral smear showing different red blood cell sizes
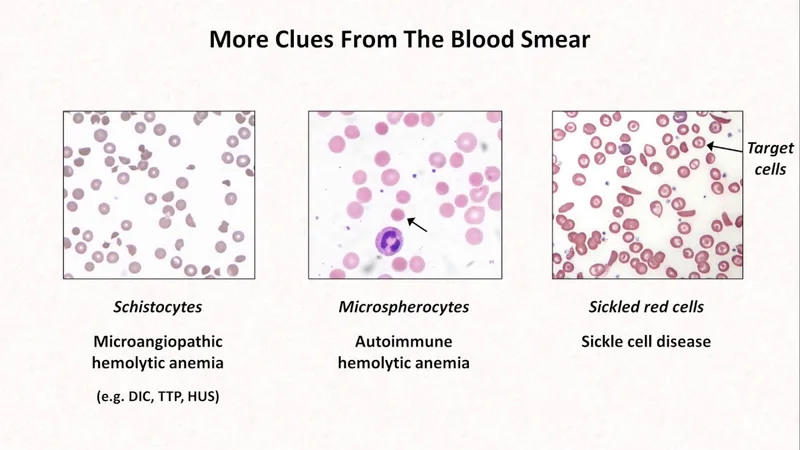
Peripheral smear findings in different types of anemia

Anemia 101 - Red Cell Rundown
- Definition: ↓ Hemoglobin (Hb) or Red Blood Cell (RBC) count below age/sex-specific normal values.
- Core Red Cell Indices:
- MCV (Mean Corpuscular Volume): RBC size; normocytic 80-100 fL.
- MCH (Mean Corpuscular Hb): Hb content per RBC.
- MCHC (Mean Corpuscular Hb Conc.): Hb concentration in RBCs.
- RDW (Red Cell Distribution Width): Index of anisocytosis (variation in RBC size).
- Reticulocytes: Immature RBCs; reflect bone marrow erythropoietic response.
- Reticulocyte Production Index (RPI): $RPI = \frac{\text{Reticulocyte %} \times \text{(Patient Hct / Normal Hct)}}{\text{Maturation Factor}}$
⭐ RPI > 2 indicates adequate marrow response (hemolysis, blood loss); RPI < 2 suggests hypoproliferation (impaired production). 
Anemia Types - Size Matters Sorting
Anemia classification starts with RBC size (Mean Corpuscular Volume, MCV), guiding diagnosis.
- Microcytic Anemia: MCV < 80 fL
- Examples: Iron Deficiency Anemia (IDA), Thalassemia, Sideroblastic anemia.
- Normocytic Anemia: MCV 80-100 fL
- Examples: Anemia of Chronic Disease (early), Acute Blood Loss, Hemolytic anemia (some).
- Macrocytic Anemia: MCV > 100 fL
- Examples: Megaloblastic anemia (B12/Folate deficiency), Liver disease, Alcoholism.
⭐ Anisocytosis (variation in RBC size) is indicated by an increased Red Cell Distribution Width (RDW), often elevated early in iron deficiency anemia.
Diagnostic Path - Sleuthing for Solutions
Systematic investigation starts with a thorough history and physical exam.
-
Initial Lab Panel:
- Complete Blood Count (CBC): Hb, Hct, RBC indices (MCV crucial: <80 fL Microcytic, 80-100 fL Normocytic, >100 fL Macrocytic), RDW.
- Reticulocyte Count: Indicates bone marrow response.
- Peripheral Smear (PS): Vital for morphological clues.
⭐ A peripheral smear examination is a crucial, cost-effective initial step that can provide significant clues to the etiology of anemia, guiding further specific tests.
-
Tiered Testing Based on MCV & PS findings:
- Microcytic (MCV <80 fL): Iron studies (serum iron, TIBC, ferritin), Hb electrophoresis.
- Normocytic (MCV 80-100 fL): Reticulocyte count. If high: hemolysis workup (LDH, bilirubin, Coombs test). If low/normal: evaluate for anemia of chronic disease, renal disease, or consider bone marrow exam if indicated.
- Macrocytic (MCV >100 fL): Vitamin B12/Folate levels, liver function tests, thyroid function tests.
Spotlight Anemias - Rogues' Gallery
- Iron Deficiency: Microcytic, hypochromic. ↓Ferritin, ↑TIBC, ↑RDW. Plummer-Vinson.
- Megaloblastic (B12/Folate): Macrocytic (MCV >100). Hypersegmented neutrophils. Neuropathy (B12).
- Thalassemia (β-major): Microcytic. Severe. "Crew-cut" X-ray. Target cells. ↑HbF, ↑HbA2.
- Sickle Cell Anemia: HbS. Vaso-occlusion, autosplenectomy. Howell-Jolly bodies. Sickling test.
- Aplastic Anemia: Pancytopenia. Hypocellular marrow. No splenomegaly.
- Hereditary Spherocytosis: AD. Spherocytes, ↑MCHC. Osmotic fragility test.
⭐ Serum ferritin is the most sensitive and specific test for iron deficiency anemia, reflecting total body iron stores.
High‑Yield Points - ⚡ Biggest Takeaways
- Anemia is a decrease in hemoglobin (Hb) or RBC count below normal reference values.
- Initial classification relies on Mean Corpuscular Volume (MCV) (microcytic, normocytic, macrocytic) and Red Cell Distribution Width (RDW).
- Common microcytic anemias include iron deficiency (most prevalent), thalassemia, and sideroblastic anemia.
- Macrocytic anemias are broadly divided into megaloblastic (Vitamin B12/folate deficiency) and non-megaloblastic types.
- Normocytic anemias often result from decreased production (e.g., aplastic anemia, CKD) or increased destruction/loss (e.g., hemolysis, acute blood loss).
- The reticulocyte count is crucial to differentiate between bone marrow production defects (low reticulocytes) and hemolysis or acute blood loss (high reticulocytes).
- Peripheral smear examination is indispensable for morphological diagnosis and provides vital clues to the underlying etiology of anemia.
Unlock the full lesson and continue reading
Signup to continue reading this lesson and unlimited access questions, flashcards, AI notes, and more